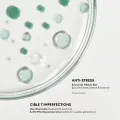

Pure Stop-Granos
PATYKA
Tratamiento localizado para neutralizar granos en menos de 24h
¿Tienes un evento importante y de pronto te ha aparecido un invitado inesperado en la cara? Que no cunda el pánico. Ten siempre a mano el tratamiento localizado Stop-Granos Patyka; es la solución de choque definitiva que actúa de forma exprés para neutralizar granos e imperfecciones en menos de 24 horas.
Gracias a su formato ultra-preciso, este gel invisible actúa directamente en el foco del problema, secando la imperfección, calmando la inflamación y evitando que quede marca. El tratamiento Stop-Granos de Patyka es precisión quirúrgica diseñada con activos purificantes para corregir el grano cuando brota. Estos son:
- Gluconolactona (PHA) Vegetal: Un polihidroxiácido que realiza una exfoliación suave pero profunda, desobstruyendo el poro y alisando la textura de la piel sin causar irritación.
- Aceite Esencial de Árbol de Té Bio: Conocido por sus potentes propiedades antibacterianas y purificantes, ayuda a neutralizar las bacterias responsables del acné de forma natural.
- Extracto de Alga Marina: Ayuda a reducir las manchas post-inflamatorias y las rojeces, asegurando que el grano desaparezca sin dejar rastro.
- Ácido Hialurónico de Bajo Peso Molecular: A diferencia de otros tratamientos secantes, este activo mantiene la hidratación de la zona tratada para favorecer la cicatrización y evitar que la piel se escame.
- Agua Celular de Menta Piperita: Aporta una sensación de frescor inmediato y ayuda a calmar el dolor y la inflamación del granito.
¿Cómo se usa? Aplica una gota directamente sobre la imperfección. Hazlo sobre la piel limpia y seca, preferiblemente por la noche para dejar que los activos actúen durante las horas de regeneración. Si la emergencia es mayor, puedes replicarlo hasta dos o tres veces a lo largo del día; al ser un gel totalmente invisible, puedes usarlo encima del maquillaje o llevarlo en el bolso para actuar en el momento exacto en que sientas que un granito empieza a asomar.

 0
0